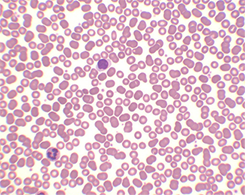

- PID
- 3016941
Automatic Slide Stainer for GRAM, Smart Auto Stainer, Smart Reagent
KS-S100G is used for GRAM.
- Award
-
- Shipping
-
- Payment
-
140+ Global Payments, trusted and secure payment provided by PayVerse.
Learn More
Detailed Description
Automatic Slide Stainer for GRAM
SMART Auto Stainer & SMART reagent
KS-S100 Series
Types of available staining methods

AFB [Ziehl-Neelsen/Kinyoun]

AFB [Fluorochrome]

GRAM
Wright-giemsa [Hematology]

Pap [Papanicolaou]

DNA

H&E
Convenient interface (User-oriented)

Features

Monitoring
Visible window allows to see inside while running.

Automatic clean
Automatic clean function is essential to sustain the trouble free status in nozzle and valve.

Fast staining
Dual-Injection type design allows fast injection and helps to take effects equally on all the slides.

Temperature monitoring
Fresh and innovative air-heating system prevents the specimens from overheat. And also you can verify the inside temperature displayed on the panel in real-time basis.

SMU (Slide Mount Unit)
Our Smart Auto Stainer can dye maximum 40 slides per cycle by using only required volume, so it is very efficient.

Save space
Reagent bottles are located just behind of the stainer to save the workspace in your lab.
Versatile instrument
The innovative design provides kinds of functions. By simply changing the setting, one stainer becomes to be another type of stainer like as GRAM stainer, Hematology stainer. And also provides all kinds of method for TB stainer like as Ziehl-Neelsen / Kinyoun, Fluorochrome
Specification
| Function | Specification |
| Slide Mount unit Capacity | 1 to 20 Slides – Total 40 Slides with option SMU |
| Pre-defined temperature | Air-heating system with real-time temperature monitoring – (60℃-70℃) |
| Staining cycle | Reagent injection (Fixing -Primary Stain -Decolorizing -Background stain -Dry) |
| Rotation Speed[rpm] | 3rpm ~ 200rpm ( Option : 1,500 ~ 2,000rpm ) |
| Basic function | Stain, Automatic Cleaning (SMU,Tube,Pump,Valve), Dry, Slide quantity setting,Reagent injection (Auto, Manual), injection volume setting, Stop |
| Electrical Requirement | 230VAC, 50Hz / Run 50W, (Heating:950W) |
| Dimension / Weight | W*D*H=507mm*554mm*274mm / approx. 20kg |
| Reagent Consumption | Approximately 0.6ml ~ 2ml / Slides |
| 1 Cycle Staining Time | 5min ~15min / vary with waiting time and slide quantity |
| SMU(Slide Mount System) | SMU I, II (option) |
Private reagent composition
| AFB [Z/N] | 1. Carbol Fuchsin 2. Decolorizer 3. Methylene Blue |
| AFB [Fluorochrome] | 1. Auramine Rhodamine 2. Decolorizer 3. Pot.Permanganate |
| GRAM | 1. Crystal Violet 2. Gram Iodine 3. Decolorizer 4. Safranin |
| Wright-giemsa [Hematology] | 1. Wright-giemsa 2. Buffer |
| Pap [Papanicolaou] | 1. Hematoxyline 2. OG-6 3. EA-50 |
| DNA | 1. Giemsa 2. Buffer |
| H&E | 1.Hematoxylin 2.Bluing Solution 3.Eosin |
We’re very pleased to introduce our company - KOREA STANDARD CO., LTD, based in South Korea.
Our company is Inno-Biz awarded company in Korean government for our innovative technology.
Our main item is automated slide stainer named Smart Auto Stainer for Gram, Hematology and TB.
We are the leader in Korean market for automated stainer. It means that our Smart Auto Stainer is already well known in the market because of its smart functionalities, although we started late.
We are proud of our engineers experienced more than 10 years in this field. So we are confident that we are the best in the world as a automated stainer manufacturer.
Now we are starting overseas marketing based on our proven state of the art technology and strong passion. We wish to invite global distributors as our business partner relating to Smart Auto Stainer in world-wide territory.




